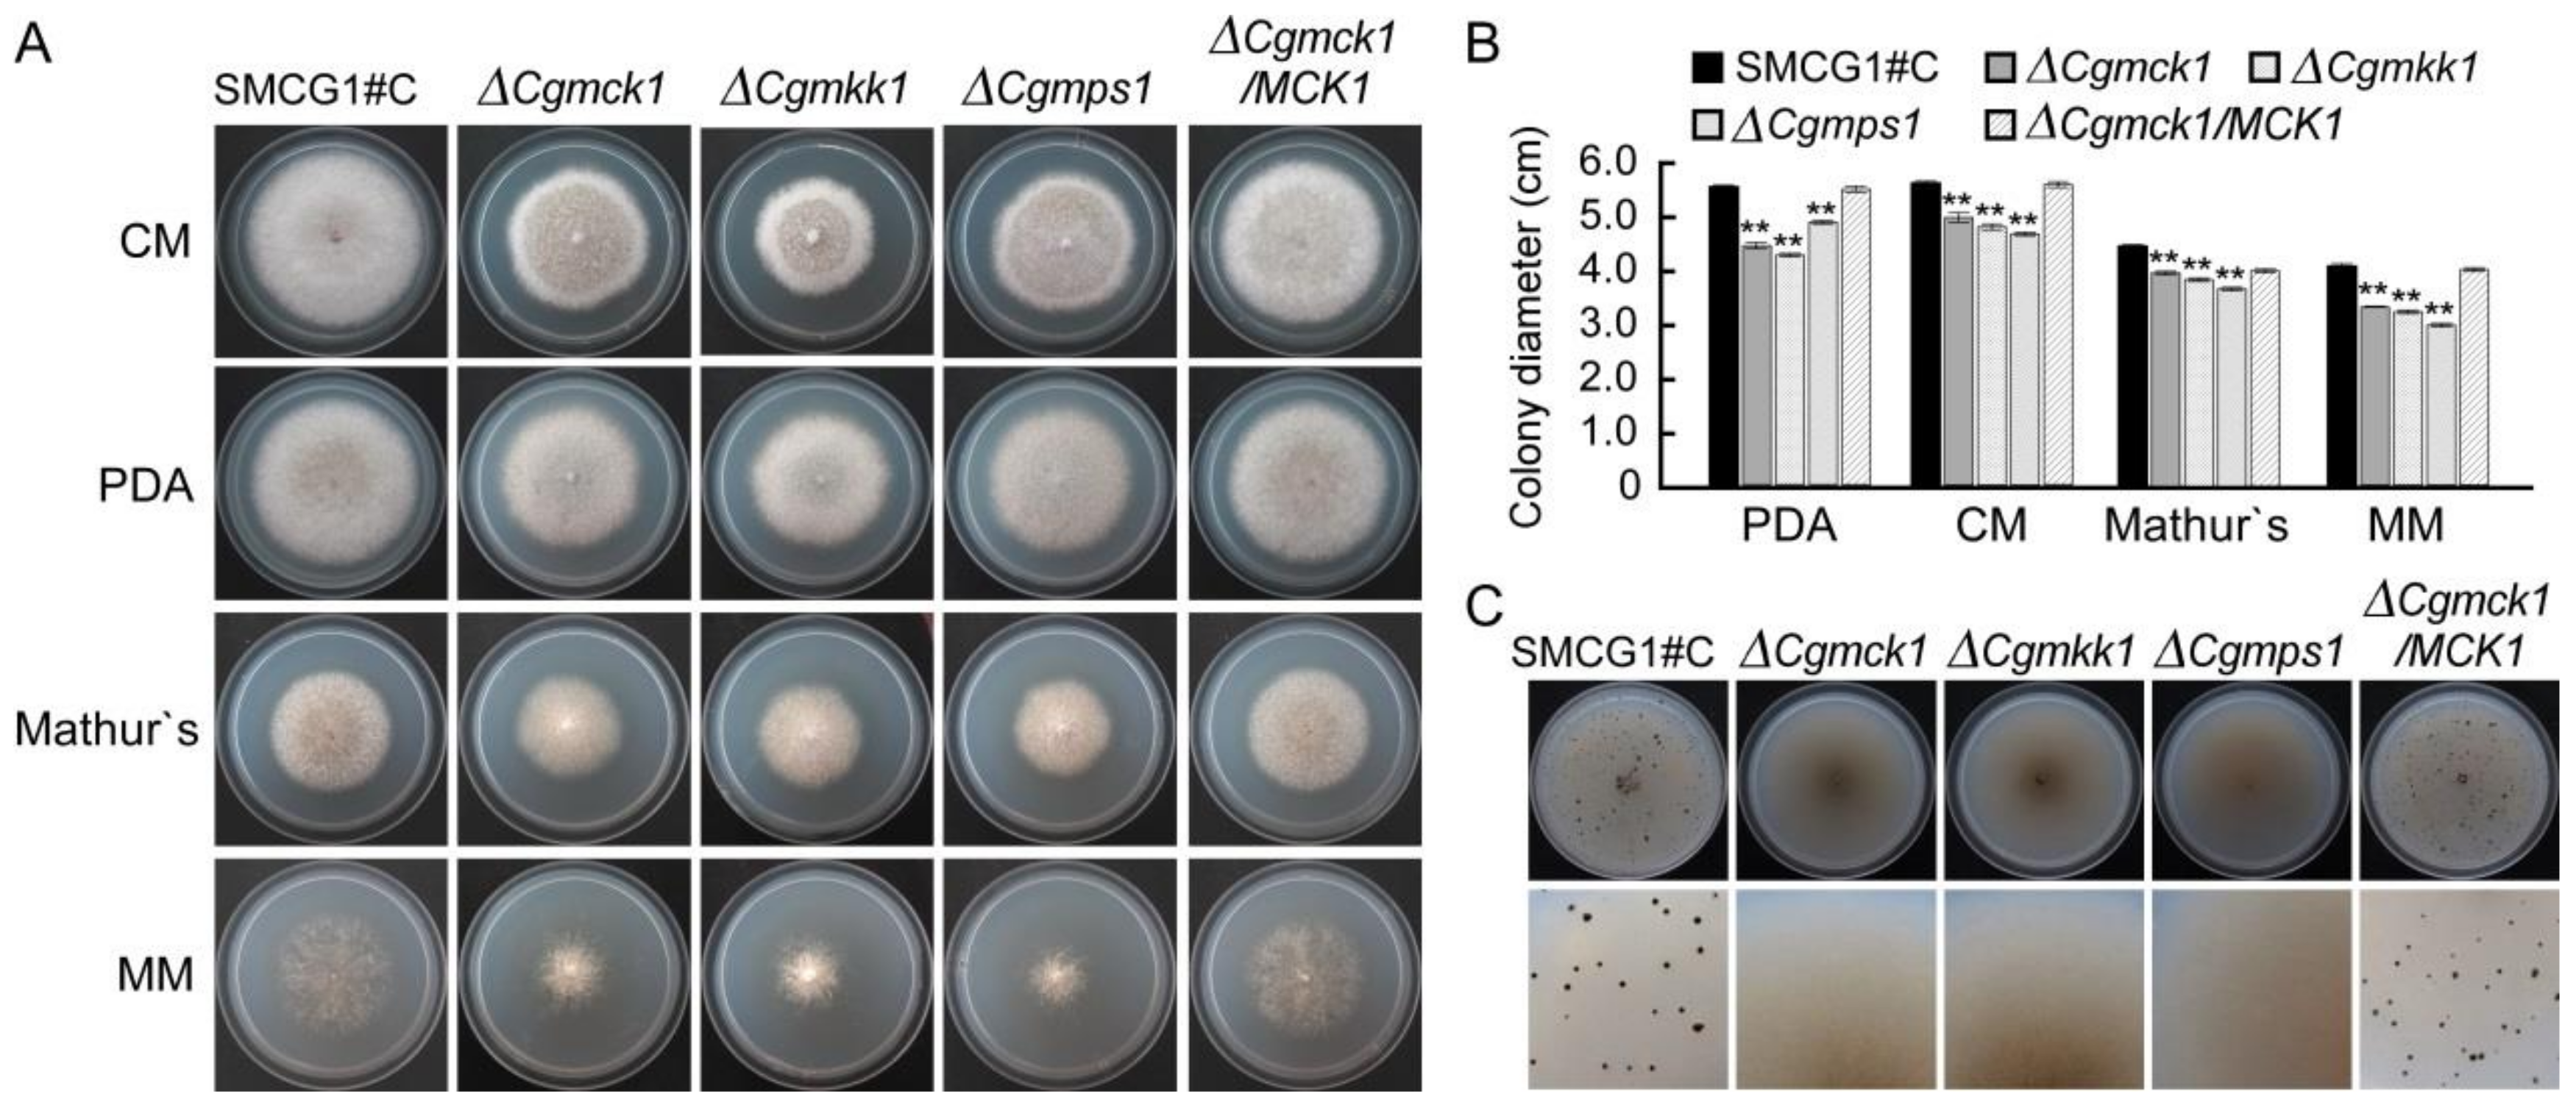
Genes 09 00543 g002
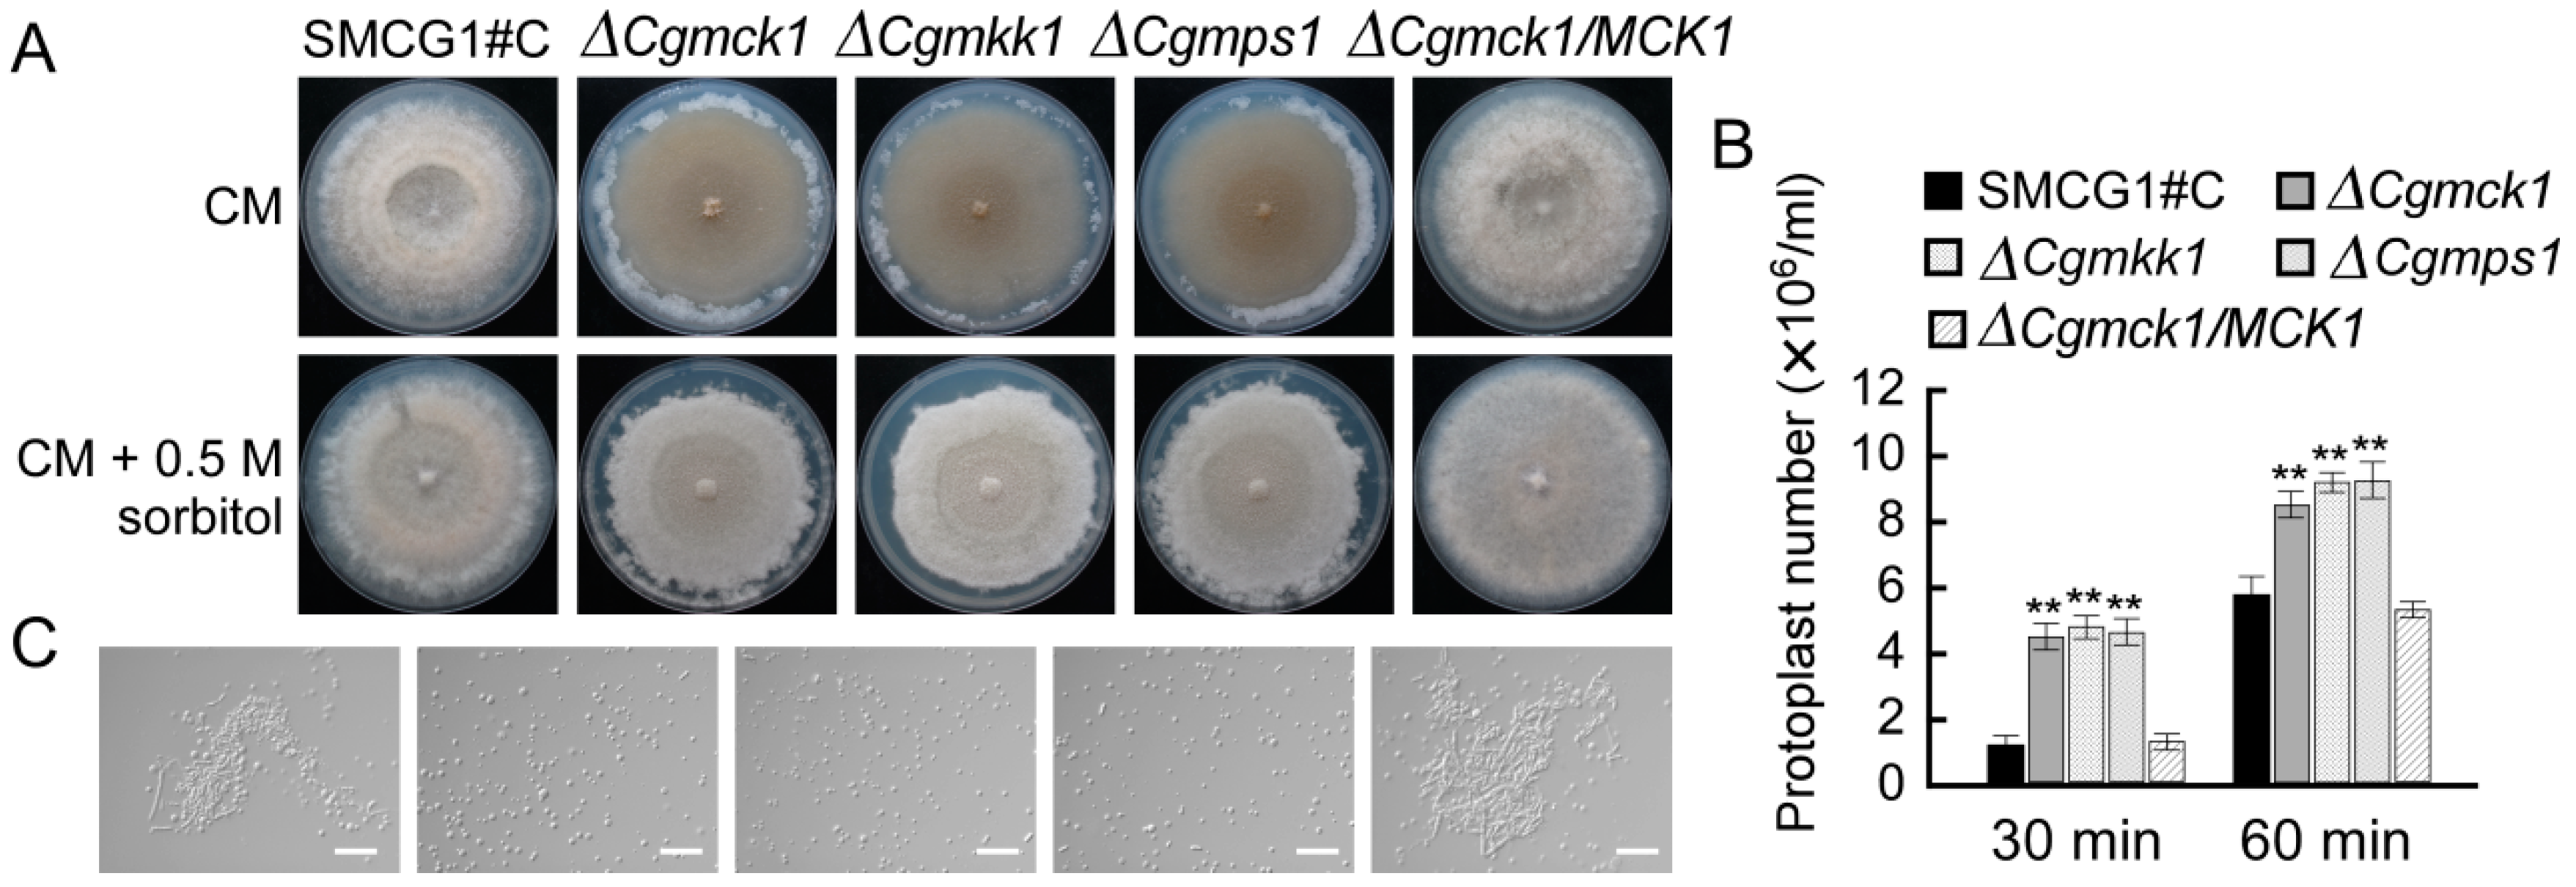
Genes 09 00543 g003

The MAPKKK CgMck1 Is Required for Cell Wall Integrity, Appressorium Development, and Pathogenicity in Colletotrichum gloeosporioides
Abstract
1. Introduction
2. Materials and Methods
2.1. Strains and Culture Conditions
2.2. Targeted Gene Deletion and Complementation
2.3. Vegetative Growth and Fruiting Body Development Assays
2.4. Various Stresses Resistance and Protoplast Release Assays
2.5. Sporulation, Conidial Germination and Appressorium Formation
2.6. Plant Infection Assays
2.7. Sensitivity Examination of Gene Deletion Mutants against Biocontrol Agents
2.8. Microscopic Observation and Statistical Analysis
3. Results
3.1. Deletion of CgMCK1 and Reintroducing CgMCK1 into ∆Cgmck1 Mutant
3.2. CgMck1 Is Important for Vegetative Growth and Fruiting Body Development
3.3. CgMck1 Is Required for Cell Wall Integrity and Osmotic Stress Resistance
3.4. CgMck1 Is Essential for Sporulation and Appressorium Formation
3.5. CgMck1 Is Required for Virulence of Colletotrichum gloeosporioides
3.6. CgMCK1 Deletion Mutant Is More Sensitive to Antagonistic Bacterium Bacillus velezensis
4. Discussion
Supplementary Materials
Author Contributions
Funding
Acknowledgments
Conflicts of Interest
References
- He, P.; Wang, Y.; Wang, X.; Zhang, X.; Tian, C. The mitogen-activated protein kinase CgMK1 governs appressorium formation, melanin synthesis, and plant infection of Colletotrichum gloeosporioides. Front. Microbiol. 2017, 8, 2216. [Google Scholar] [CrossRef] [PubMed]
- Xu, J.R. Map kinases in fungal pathogens. Fungal Genet. Biol. 2000, 31, 137–152. [Google Scholar] [CrossRef] [PubMed]
- Lesage, G.; Bussey, H. Cell wall assembly in Saccharomyces cerevisiae. Microbiol. Mol. Biol. Res. 2006, 70, 317–343. [Google Scholar] [CrossRef] [PubMed]
- Levin, D.E. Cell wall integrity signaling in Saccharomyces cerevisiae. Microbiol. Mol. Biol. Res. 2005, 69, 262–291. [Google Scholar] [CrossRef] [PubMed]
- Jiménez-Sánchez, M.; Jiménez-Sánchez, M.; Cid, V.J.; Molina, M. Retrophosphorylation of Mkk1 and Mkk2 MAPKKs by the Slt2 MAPK in the yeast cell integrity pathway. J. Biol. Chem. 2007, 282, 31174–31185. [Google Scholar] [CrossRef] [PubMed]
- Jendretzki, A.; Wittland, J.; Wilk, S.; Straede, A.; Heinisch, J.J. How do I begin? Sensing extracellular stress to maintain yeast cell wall integrity. Eur. J. Cell Biol. 2011, 90, 740–744. [Google Scholar] [CrossRef] [PubMed]
- Jeon, J.; Goh, J.; Yoo, S.; Chi, M.H.; Choi, J.; Rho, H.S.; Park, J.; Han, S.S.; Kim, B.R.; Park, S.Y.; et al. A putative MAP kinase kinase kinase, MCK1, is required for cell wall integrity and pathogenicity of the rice blast fungus, Magnaporthe oryzae. Mol. Plant-Microbe Interact. 2008, 21, 525–534. [Google Scholar] [CrossRef] [PubMed]
- Yin, Z.; Tang, W.; Wang, J.; Liu, X.; Yang, L.; Gao, C.; Zhang, J.; Zhang, H.; Zheng, X.; Wang, P.; et al. Phosphodiesterase MoPdeH targets MoMck1 of the conserved mitogen-activated protein (MAP) kinase signalling pathway to regulate cell wall integrity in rice blast fungus Magnaporthe oryzae. Mol. Plant Pathol. 2016, 17, 654–668. [Google Scholar] [CrossRef] [PubMed]
- Xu, J.R.; Staiger, C.J.; Hamer, J.E. Inactivation of the mitogen-activated protein kinase Mps1 from the rice blast fungus prevents penetration of host cells but allows activation of plant defense responses. Proc. Natl. Acad. Sci. USA 1998, 95, 12713–12718. [Google Scholar] [CrossRef] [PubMed]
- Ding, Z.; Li, M.; Sun, F.; Xi, P.; Sun, L.; Zhang, L.; Jiang, Z. Mitogen-activated protein kinases are associated with the regulation of physiological traits and virulence in Fusarium oxysporum f. sp. cubense. PLoS ONE 2015, 10, e0122634. [Google Scholar] [CrossRef] [PubMed]
- Yago, J.I.; Lin, C.H.; Chung, K.R. The SLT2 mitogen-activated protein kinase-mediated signalling pathway governs conidiation, morphogenesis, fungal virulence and production of toxin and melanin in the tangerine pathotype of Alternaria alternata. Mol. Plant Pathol. 2011, 12, 653–665. [Google Scholar] [CrossRef] [PubMed]
- Dean, R.; van Kan, J.A.; Pretorius, Z.A.; Hammond-Kosack, K.E.; Di Pietro, A.; Spanu, P.D.; Rudd, J.J.; Dickman, M.; Kahmann, R.; Ellis, J.; et al. The top 10 fungal pathogens in molecular plant pathology. Mol. Plant Pathol. 2012, 13, 414–430. [Google Scholar] [CrossRef] [PubMed]
- Xu, X.; Wang, Y.; Tian, C.; Liang, Y. The Colletotrichum gloeosporioides RhoB regulates cAMP and stress response pathways and is required for pathogenesis. Fungal Genet. Biol. 2016, 96, 12–24. [Google Scholar] [CrossRef] [PubMed]
- Huang, L.; Li, Q.; Zhang, Y.; Li, D.; Ye, J. Colletotrichum gloeosporioides sensu stricto is a pathogen of leaf anthracnose on evergreen spindle tree (Euonymus japonicus). Plant Dis. 2016, 100, 672–678. [Google Scholar] [CrossRef]
- Priyatno, T.P.; Abu Bakar, F.D.; Kamaruddin, N.; Mahadi, N.M.; Abdul Murad, A.M. Inactivation of the catalytic subunit of cAMP-dependent protein kinase A causes delayed appressorium formation and reduced pathogenicity of Colletotrichum gloeosporioides. Sci. World J. 2012, 545784. [Google Scholar]
- Kim, Y.K.; Kawano, T.; Li, D.; Kolattukudy, P.E. A mitogen-activated protein kinase kinase required for induction of cytokinesis and appressorium formation by host signals in the conidia of Colletotrichum gloeosporioides. Plant Cell 2000, 12, 1331–1343. [Google Scholar] [CrossRef] [PubMed]
- Yong, H.Y.; Bakar, F.D.; Illias, R.M.; Mahadi, N.M.; Murad, A.M. Cgl-SLT2 is required for appressorium formation, sporulation and pathogenicity in Colletotrichum gloeosporioides. Braz. J. Microbiol. 2013, 44, 1241–1250. [Google Scholar] [CrossRef] [PubMed]
- Huang, L.; Yang, J.; Fang, Y.; Li, Q.; Liang, Y.; Ye, J. Efficient genetic transformation and nuclear behavior during the process of appressorial development in Colletotrichum gloeosporioides. J. Nanjing For. Univ. (Natl. Sci. Ed.) 2017, 41, 68–72. [Google Scholar]
- Huang, L.; Zhang, S.; Yin, Z.; Liu, M.; Li, B.; Zhang, H.; Zheng, X.; Wang, P.; Zhang, Z. MoVrp1, a putative verprolin protein, is required for asexual development and infection in the rice blast fungus Magnaporthe oryzae. Sci. Rep. 2017, 7, 41148. [Google Scholar] [CrossRef] [PubMed]
- Huang, L.; Kim, K.; Yang, J.; Song, H.; Choi, G.; Jeon, J.; Cheong, K.; Ko, J.; Xu, H.; Lee, Y. A high-quality draft genome sequence of Colletotrichum gloeosporioides s.s. SMCG1#C, a causal agent of anthracnose on Cunninghamia lanceolata in China. Mol. Plant-Microbe Interact. 2018. [Google Scholar] [CrossRef]
- Lim, Y.; Kim, K.; Lee, Y. SUMOylation is required for fungal development and pathogenicity in the rice blast fungus Magaporthe oryzae. Mol. Plant Pathol. 2018, 19, 2134–2148. [Google Scholar] [CrossRef] [PubMed]
- Yang, J.; Fang, Y.; Wang, P.; Ye, J.; Huang, L. Pleiotropic roles of ChSat4 in asexual development, cell wall integrity maintenance, and pathogenicity in Colletotrichum higginsianum. Front. Microbiol. 2018, 9, 2311. [Google Scholar] [CrossRef]
- Huang, L.; Li, Q.C.; Hou, Y.; Li, G.Q.; Yang, J.Y.; Li, D.W. Bacillus velezensis strain HYEB5-6 as a potential biocontrol agent against anthracnose on Euonymus japonicus. Biocontrol Sci. Technol. 2017, 27, 636–653. [Google Scholar] [CrossRef]
- Elliott, C.E.; Howlett, B.J. Mutation of a gene in the fungus Leptosphaeria maculans allows increased frequency of penetration of stomatal apertures of Arabidopsis thaliana. Mol. Plant 2008, 1, 471–481. [Google Scholar] [CrossRef] [PubMed]
- Li, Y.; Geng, X.; Ji, P.; Pan, C.; Wei, S. Isolation and evaluation of a strain for control of corn stalk rot. Biocontrol Sci. Technol. 2016, 26, 1–13. [Google Scholar] [CrossRef]
- Romero, F.M.; Marina, M.; Pieckenstain, F.L. Novel components of leaf bacterial communities of field-grown tomato plants and their potential for plant growth promotion and biocontrol of tomato diseases. Res. Microbiol. 2016, 167, 222–233. [Google Scholar] [CrossRef] [PubMed]
- Yuan, S.; Wang, L.; Wu, K.; Shi, J.; Wang, M.; Yang, X.; Shen, Q.; Shen, B. Evaluation of Bacillus-fortified organic fertilizer for controlling tobacco bacterial wilt in greenhouse and field experiments. Appl. Soil Ecol. 2014, 75, 86–94. [Google Scholar] [CrossRef]
- Carbó, N.; Pérez-Martín, J. Activation of the cell wall integrity pathway promotes escape from G2 in the fungus Ustilago maydis. PLoS Genet. 2010, 6, e1001009. [Google Scholar] [CrossRef] [PubMed]
- Fuchs, B.B.; Mylonakis, E. Our paths might cross: The role of the fungal cell wall integrity pathway in stress response and cross talk with other stress response pathways. Eukaryot. Cell 2009, 8, 1616–1625. [Google Scholar] [CrossRef] [PubMed]
- Kamada, Y.; Qadota, H.; Python, C.P.; Anraku, Y.; Ohya, Y.; Levin, D.E. Activation of yeast protein kinase C by Rho1 GTPase. J. Biol. Chem. 1996, 271, 9193–9196. [Google Scholar] [CrossRef] [PubMed]
- Nonaka, H.; Tanaka, K.; Hirano, H.; Fujiwara, T.; Kohno, H.; Umikawa, M.; Mino, A.; Takai, Y. A downstream target of RHO1 small GTP-binding protein is PKC1, a homolog of protein kinase C, which leads to activation of the MAP kinase cascade in Saccharomyces cerevisiae. EMBO J. 1995, 14, 5931–5938. [Google Scholar] [CrossRef] [PubMed]
- Banuett, F.; Herskowitz, I. Identification of fuz7, a Ustilago maydis MEK/MAPKK homolog required for a-locus-dependent and -independent steps in the fungal life cycle. Genes Dev. 1994, 8, 1367–1378. [Google Scholar] [CrossRef] [PubMed]
- Dodou, E.; Treisman, R. The Saccharomyces cerevisiae MADS-box transcription factor Rlm1 is a target for the Mpk1 mitogen-activated protein kinase pathway. Mol. Cell. Biol. 1997, 17, 1848–1859. [Google Scholar] [CrossRef] [PubMed]
- Madden, K.; Sheu, Y.J.; Baetz, K.; Andrews, B.; Snyder, M. SBF cell cycle regulator as a target of the yeast PKC-MAP kinase pathway. Science 1997, 275, 1781–1784. [Google Scholar] [CrossRef] [PubMed]
- Qi, Z.; Wang, Q.; Dou, X.; Wang, W.; Zhao, Q.; Lv, R.; Zhang, H.F.; Zheng, X.; Wang, P.; Zhang, Z. MoSwi6, an APSES family transcription factor, interacts with MoMps1 and is required for hyphal and conidial morphogenesis, appressoriv8l function and pathogenicity of Magnaporthe oryzae. Mol. Plant Pathol. 2012, 13, 677–689. [Google Scholar] [CrossRef] [PubMed]
- Donlin, M.J.; Upadhya, R.; Gerik, K.J.; Lam, W.; Van Arendonk, L.G.; Specht, C.A.; Sharma, N.K.; Lodge, J.K. Cross talk between the cell wall integrity and cyclic AMP/protein kinase A pathways in Cryptococcus neoformans. mBio 2014, 5, e01573-14. [Google Scholar] [CrossRef] [PubMed]
- Gerik, K.J.; Donlin, M.J.; Soto, C.E.; Banks, A.M.; Banks, I.R.; Maligie, M.A.; Selitrennikoff, C.P.; Lodge, J.K. Cell wall integrity is dependent on the PKC1 signal transduction pathway in Cryptococcus neoformans. Mol. Microbiol. 2005, 58, 393–408. [Google Scholar] [CrossRef] [PubMed]
- Kraus, P.R.; Fox, D.S.; Cox, G.M.; Heitman, J. The Cryptococcus neoformans MAP kinase Mpk1 regulates cell integrity in response to antifungal drugs and loss of calcineurin function. Mol. Microbiol. 2003, 48, 1377–1387. [Google Scholar] [CrossRef] [PubMed]
- Madrigal, C.; Tadeo, J.L.; Melgarejo, P. Relationship between flavipin production by Epicoccum nigrum and antagonism against Monilinia laxa. Mycol. Res. 1991, 95, 1375–1381. [Google Scholar] [CrossRef]
- Li, Y.; Xia, L.Q.; Wang, Y.N.; Liu, X.Y.; Zhang, C.H.; Hu, T.L.; Cao, K.Q. The inhibitory effect of Epicoccum nigrum strain XF1 against Phytophthora infestans. Biol. Control 2013, 67, 462–468. [Google Scholar] [CrossRef]
- Perveen, I.; Raza, M.A.; Iqbal, T.; Naz, I.; Sehar, S.; Ahmed, S. Isolation of anticancer and antimicrobial metabolites from Epicoccum nigrum; endophyte of Ferula sumbul. Microb. Pathog. 2017, 110, 214–224. [Google Scholar] [CrossRef] [PubMed]
- Han, J.; Shim, H.; Shin, J.; Kim, K.S. Antagonistic activities of Bacillus spp. strains isolated from tidal flat sediment towards anthracnose pathogens Colletotrichum acutatum and C. gloeosporioides in South Korean. Plant Pathol. J. 2015, 31, 165–175. [Google Scholar] [CrossRef] [PubMed]
- Zhang, C.; Wang, J.; Tao, H.; Dang, X.; Wang, Y.; Chen, M.; Zhai, Z.; Yu, W.; Xu, L.; Shim, W.B.; et al. FvBck1, a component of cell wall integrity MAP kinase pathway, is required for virulence and oxidative stress response in sugarcane Pokkah Boeng pathogen. Front. Microbiol. 2015, 8, 1096. [Google Scholar] [CrossRef] [PubMed]
- Horbach, R.; Navarro-Quesada, A.R.; Knogge, W.; Deising, H.B. When and how to kill a plant cell: Infection strategies of plant pathogenic fungi. J. Plant Physiol. 2011, 168, 51–62. [Google Scholar] [CrossRef] [PubMed]
- De Silva, D.D.; Crous, P.W.; Ades, P.K.; Hyde, K.D.; Taylor, P.W.J. Life styles of Colletotrichum species and implications for plant biosecurity. Fungal Biol. Res. 2017, 31, 155–168. [Google Scholar] [CrossRef]
- Yue, X.; Que, Y.; Xu, L.; Deng, S.; Peng, Y.; Talbot, N. ZNF1 encodes a putative C2H2 zinc finger protein essential for appressorium differentiation by the rice blast fungus Magnaporthe oryzae. Mol. Plant-Microbe Interact. 2015, 29, 22–35. [Google Scholar] [CrossRef] [PubMed]
- Xu, J.R.; Hamer, J.E. MAP kinase and cAMP signaling regulate infection structure formation and pathogenic growth in the rice blast fungus Magnaporthe grisea. Genes Dev. 1996, 10, 2696–2706. [Google Scholar] [CrossRef] [PubMed]
- Takano, Y.; Kikuchi, T.; Kubo, Y.; Hamer, J.E.; Mise, K.; Furusawa, I. The Colletotrichum lagenarium MAP kinase gene CMK1 regulates diverse aspects of fungal pathogenesis. Mol. Plant-Microbe Interact. 2000, 13, 374–383. [Google Scholar] [CrossRef] [PubMed]
- Kojima, K.; Kikuchi, T.; Takano, Y.; Takano, Y.; Oshiro, E.; Okuno, T. The mitogen-activated protein kinase gene MAF1 is essential for the early differentiation phase of appressorium formation in Colletotrichum lagenarium. Mol. Plant-Microbe Interact. 2002, 15, 1268–1276. [Google Scholar] [CrossRef] [PubMed]
- Ludwig, N.; Löhrer, M.; Hempel, M.; Mathea, S.; Schliebner, I.; Menzel, M.; Kiesow, A.; Schaffrath, U.; Deising, H.B.; Horbach, R. Melanin is not required for turgor generation but enhances cell-wall rigidity in appressoria of the corn pathogen Colletotrichum graminicola. Mol. Plant-Microbe Interact. 2014, 27, 315–327. [Google Scholar] [CrossRef] [PubMed]

| Strain | 0.005% SDS | 50 μg/mL CFW | 100 μg/mL CFW | 200 μg/mL CR | 600 μg/mL CR | 0.7M NaCl | 1M Sorbitol |
|---|---|---|---|---|---|---|---|
| SMCG 1#C | 47.9 ± 0.36 B | 12.0 ± 0.8 C | 16.9 ± 1.6 D | 32.3 ± 2.0 C | 49.8 ± 1.0 D | 38.1 ± 0.5 B | 22.2 ± 1.3 B |
| ∆Cgmck1 | 54.3 ± 2.01 A | 20.7 ± 0.6 B | 27.9 ± 0.8 C | 53.1 ± 0.9 A | 53.8 ± 0.2 C | 35.4 ± 0.6 C | 30.1 ± 1.0 A |
| ∆Cgmkk1 | 55.6 ± 1.04 A | 21.8 ± 2.0 B | 31.7 ± 0.4 B | 42.9 ± 1.0 B | 61.1 ± 1.8 A | 35.8 ± 0.6 C | 26.9 ± 1.0 A |
| ∆Cgmps1 | 51.8 ± 0.22 A | 24.5 ± 1.4 A | 37.0 ± 3.1 A | 42.8 ± 1.0 B | 56.5 ± 1.0 B | 39.8 ± 0.3 A | 27.4 ± 1.0 A |
| ∆Cgmck1/CgMCK1 | 49.0 ± 0.38 B | 12.3 ± 0.4 C | 16.3 ± 0.4 D | 32.8 ± 1.0 C | 50.5 ± 0.2 D | 38.3 ± 0.5 B | 24.1 ± 0.6 B |
| ∆Cgmkk1/CgMKK1 | 48.1 ± 2.83 B | 12.7 ± 1.5 C | 17.1 ± 0.6 D | 33.1 ± 0.9 C | 51.2 ± 3.1 D | 36.6 ± 0.4 B | 24.8 ± 1.1 B |
| ∆Cgmps1/CgMPS1 | 49.5 ± 0.28 B | 13.9 ± 0.4 C | 19.5 ± 0.4 D | 33.3 ± 1.1 C | 51.1 ± 0.9 D | 37.7 ± 0.3 B | 23.2 ± 1.3 B |
© 2018 by the authors. Licensee MDPI, Basel, Switzerland. This article is an open access article distributed under the terms and conditions of the Creative Commons Attribution (CC BY) license (http://creativecommons.org/licenses/by/4.0/).
Share and Cite
Fang, Y.-L.; Xia, L.-M.; Wang, P.; Zhu, L.-H.; Ye, J.-R.; Huang, L. The MAPKKK CgMck1 Is Required for Cell Wall Integrity, Appressorium Development, and Pathogenicity in Colletotrichum gloeosporioides. Genes 2018, 9, 543. https://doi.org/10.3390/genes9110543
Fang Y-L, Xia L-M, Wang P, Zhu L-H, Ye J-R, Huang L. The MAPKKK CgMck1 Is Required for Cell Wall Integrity, Appressorium Development, and Pathogenicity in Colletotrichum gloeosporioides. Genes. 2018; 9(11):543. https://doi.org/10.3390/genes9110543
Chicago/Turabian StyleFang, Yu-Lan, Li-Ming Xia, Ping Wang, Li-Hua Zhu, Jian-Ren Ye, and Lin Huang. 2018. "The MAPKKK CgMck1 Is Required for Cell Wall Integrity, Appressorium Development, and Pathogenicity in Colletotrichum gloeosporioides" Genes 9, no. 11: 543. https://doi.org/10.3390/genes9110543
APA StyleFang, Y.-L., Xia, L.-M., Wang, P., Zhu, L.-H., Ye, J.-R., & Huang, L. (2018). The MAPKKK CgMck1 Is Required for Cell Wall Integrity, Appressorium Development, and Pathogenicity in Colletotrichum gloeosporioides. Genes, 9(11), 543. https://doi.org/10.3390/genes9110543





